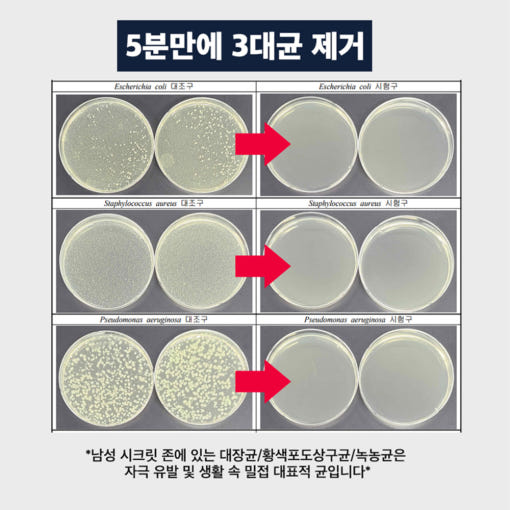
thumbnail-3

NAVER
The AromaShop オーガニックシークレット男性用 100ml メンズ股間アナル Mゾーンクリーンミスト
더아로마샵 유기농 시크릿 포맨 100ml 남성 사타구니 항문 M존 청결 미스트
33% OFF
¥2,481
¥1,680
通常韓国商品
韓国の素敵な商品をすぐにお届けします。
必須
商品オプション選択
商品オプションご要望
この商品はいかがですか?
注文配送の流れ
一目で見る

ご注文前に知っておきたいこと
在庫および発送に関するご案内
SAZOは購入代行サービスを提供しているため、商品の在庫は保有しておりません。
配送不可商品について
以下の商品は配送できませんので、あらかじめご了承ください。
乳製品、生もの、冷凍商品、賞味期限が短い商品、海外発送商品(韓国以外)、通関不可商品、レンタル品。
通関禁止項目に該当する場合、税関で破棄される可能性があります。ご購入前に、輸入の可否について必ずお客様ご自身でご確認ください。
不具合発生時の迅速な対応
商品に不具合や欠陥が見つかった場合は、写真と詳細内容を添えてご連絡いただければ、速やかに返金対応が可能です。
なぜSAZOなのか?